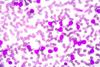
shutterstock_264150389

All Drug Development articles – Page 6
-
News
Teva wins US obesity approval for its GLP-1 generic liraglutide
And Eli Lilly and Company’s new oral GLP-1 obesity therapy orforglipron shines in late-phase clinical trials.
-
 News
NewsPharmacopeial Discussion Group releases major particulate contamination update
Revisions to the harmonised general chapter “Particulate Contamination (Q-09)” aim to improve pharmaceutical drug development.
-
News
Late-stage trial boost for Argenx’s myasthenia gravis drug Vyvgart
The Phase III findings could represent a critical advancement in managing the rare autoimmune disease in those with limited treatment options.
-
 News
NewsNanoscope gene therapy data signals potential retinal disease advancement
Further to its potential in Stargardt disease, if approved, the one-time gene therapy could become standard of care for retinitis pigmentosa, alongside other retinal degenerative diseases.
-
 Article
ArticleScaling for the GLP-1 revolution - meeting global injectable demand
In this article, Miguel Angel Ortega Sánchez of ROIS explores how the industry is adapting to new delivery formats, device bottlenecks, and strategic partnership models — and why flexibility, compliance, and tech transfer agility are now critical to success.
-
 News
NewsSanofi’s Tzield type 1 diabetes immunotherapy wins UK first
Becomes the first monoclonal antibody for the condition to be approved by the MHRA and advances the pharma company’s ambitions in diabetes.
-
 Webinar
WebinarThe future of contamination control in pharma: from compliance to innovation
This webinar explores the benefits of accelerated microbial identification using MALDI-TOF in pharmaceutical contamination control strategies.
-
 News
NewsDaewoong's microneedle patch marks semaglutide first in obesity
Pharmacokinetic study of the novel drug delivery method shows high relative bioavailability in a once-weekly regimen.
-
 Whitepaper
WhitepaperTCS revolutionize clinical trial monitoring and data analysis with AR/VR-driven immersive analytics
AR/VR solution for visualizing multi-dimensional data in 3D. Explore sites on a 3D globe to detect trends and anomalies with ease.
-
 Webinar
WebinarBest practices for PUPSIT assembly design and operation
This webinar explores the design and implementation of pre use post sterilisation integrity test assemblies (PUPSIT) in sterile filtration processes to ensure regulatory compliance while minimising operational risk.
-
 News
NewsBiowaste innovation could advance green pharmaceutical production
The novel approach could reduce the industry’s reliance on fossil fuels by offering a sustainable production alternative for pharmaceuticals.
-
 News
NewsNew AbbVie data highlights Rinvoq promise in alopecia areata
The trial is the first pivotal clinical programme to have met the standard of complete scalp hair regrowth, suggesting potential in immune-mediated diseases.
-
News
Sandoz acquisition to boost in-house biosimilar capabilities
The proposed transaction means Just-Evotec Biologics’ Toulouse site would be used to develop and manufacture Sandoz biosimilars.
-
 News
NewsExtension trial demonstrates long-term benefit for Lilly Alzheimer's drug
The new findings support a limited duration dosing approach and highlight the consistent safety profile for Eli Lilly’s antibody drug.
-
 News
NewsBristol Myers Squibb names new Head of Development
The new appointee has over twenty years of experience in biopharma and extensive senior expertise in oncology.
-
 Report
ReportPharma Horizons: leading-edge formulation
This report addresses the key factors shaping pharmaceutical formulation, including regulation, QC and analysis.
-
 Article
ArticleWhat will shape the Pharma landscape in Q3 2025?
Upcoming drug approvals and clinical progress will be pivotal during the third quarter of the year, says GlobalData.
-
News
NewsStanford research illustrates safer stem cell transplants for genetic disease
The innovative protocol could improve stem cell transplants and make them safer, enabling a broader disease population to take advantage of the benefits.
-
 News
NewsSanofi $1.6 billion acquisition to advance respiratory vaccines
The new deal could support innovation of next-generation combination vaccines to protect older adults against multiple respiratory viruses.
-
 News
NewsMHRA approves needle-free allergy drug alternative
The MHRA's approval provides eligible patients with a novel delivery method that is convenient and non-invasive.



